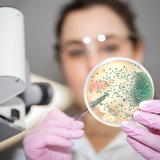
Caprylic Acid Combination

Discover
Support your intestinal health and maintain balance in your flora levels- Supports intestinal health and balance.
How It Works

How It Works
This formula is designed to nutritionally support the needs of those who want to maintain optimal balance in their friendly flora.
Ingredients

What's Inside
Active Ingredients
Caprylic acid, elecampane root, black walnut hulls and red raspberry leaves.
How to Use

How to Use
DirectionsTake 2 capsules with a meal.
Frequency
2x daily